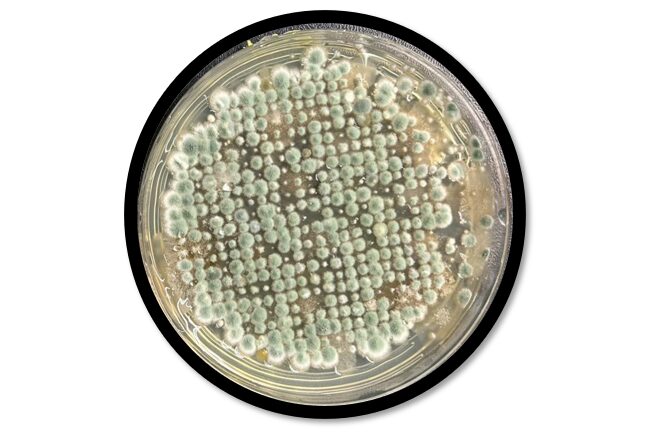

宿泊利用のある法人施設の居室で、壁まわりやベッド周辺にカビが見られるとのご相談を受け、ハーツリッチ株式会社(ハーツクリーン事業部)が現地調査を実施しました。
カビは、見えている変色部分だけを清掃しても、発生原因が残っていると再発しやすいものです。
とくに居室のように人が長時間過ごす空間では、空気中のカビ、表面に付着した菌、建材の水分状態をあわせて確認することが重要です。
今回は、目視確認に加えて、付着菌検査・浮遊菌調査・含水率測定を行い、汚染の広がり方と背景要因を多角的に確認しました。
1. 今回の調査で行ったこと

今回の調査では、カビの発生状況と原因を把握するため、複数の検査を組み合わせて実施しました。
1-1. 表面汚染を確認する付着菌検査
ベッド裏面、壁面、クロス裏、ボード裏などから菌を採取し、付着している菌数を確認しました。
付着菌汚染度の目安は次の通りです。
| 菌数(CFU/100cm²) | 判定 |
|---|---|
| 1〜500 | 清潔 |
| 501〜3,000 | 注意 |
| 3,001以上 | 汚染 |
1-2. 空気中のカビを確認する浮遊菌調査
室内と天井裏の空気を採取し、寒天培地による培養調査を実施しました。
これにより、目に見える汚れだけでなく、空間内に広がっているカビの量や種類の傾向を確認しました。
浮遊菌汚染度の目安は次の通りです。
| 区分 | 判定基準(CFU/100L) |
|---|---|
| 清潔区域 | 5 以下 |
| 準清潔区域 | 20 以下 |
| 準汚染区域 | 21〜99 |
| 汚染区域 | 100 以上 |
1-3. 建材の状態を確認する含水率測定
洗面・水まわり周辺やベッド周辺の建材について、含水率を測定しました。
石膏ボード系部材は、一般的に次のように判断します。
| 含水率 | 状態の目安 |
|---|---|
| 0〜1%未満 | 乾燥 |
| 1〜2%未満 | やや湿気あり |
| 2%以上 | 濡れ |
1-4. 目視による周辺確認
数値による検査とあわせて、現地では目視による状況確認も行いました。
点検口まわり、ユニットバス内、クロス表面・裏面、ベッドフレーム裏など、見えにくい部位まで対象を広げ、汚れの広がり方や発生箇所の傾向を確認しました。
2. 付着菌検査の結果|ボード裏とベッド裏で高い菌数を確認
付着菌検査では、見えている表面よりも、裏側や隠れた部分で高い菌数が確認されました。
一部では、「汚染」の目安である3,001以上を大きく上回る数値も確認されました。
| 測定箇所 | 総菌数 | 評価 |
|---|---|---|
| 居室A ベッド裏面 | 6,650 | 汚染 |
| 居室A 壁面 | 2,970 | 注意 |
| 居室A 壁面(変色箇所) | 80 | 清潔 |
| 居室A クロス裏 | 0 | 清潔 |
| 居室A ボード裏 | 7,160 | 汚染 |
| 居室B ベッド裏面 | 1,400 | 注意 |
| 居室B 壁面 | 70 | 清潔 |
| 居室B 壁面(変色箇所) | 1,640 | 注意 |
| 居室B クロス裏 | 120 | 清潔 |
| 居室B ボード裏 | 8,770 | 汚染 |
特にボード裏は両居室とも高い数値で、表面からは見えにくい場所が汚染源の一つになっていた可能性が考えられます。
一方で、クロス裏の数値は低く、見た目の印象だけでは汚染の中心を判断できないことも分かりました。
3. 浮遊菌調査の結果|室内・天井裏で高い数値を確認
浮遊菌調査では、室内と天井裏の各測定箇所で、いずれも100CFU/100Lを超える数値が確認されました。
今回調査した範囲では、すべての測定箇所が汚染区域に相当しており、空気中にもカビの影響が及んでいたことがうかがえます。
| 調査箇所 | 浮遊カビ数 | 評価 |
|---|---|---|
| 居室A 室内 | 2,350 | 汚染区域 |
| 居室A 天井裏 | 270 | 汚染区域 |
| 居室B 室内 | 1,850 | 汚染区域 |
| 居室B 天井裏 | 1,680 | 汚染区域 |
培養では、アスペルギルス属、ペニシリウム属、クラドスポリウム属、アルタナリア属などが確認されました。
また、変色箇所の培養では、黒カビとして知られる菌も確認されており、見えている表面だけでなく、空間全体や見えない内部にもカビ由来の負荷が残っている可能性が示唆されました。
4. カビの状況写真|見えにくい部位にも汚染の広がりを確認
現地では、菌数測定だけでなく、各所の目視確認と写真記録も行いました。
その結果、点検口まわりやユニットバス内、ベッドフレーム裏など、日常的には見えにくい部位にもカビの広がりが確認されました。
4-1. 点検口まわりの状況

点検口裏や点検口内では、表面の汚れだけでは把握しにくいカビの付着が見られました。
こうした部位は普段確認しにくいため、汚染が進んでいても気づきにくい場所の一つです。
4-2. ユニットバス内の状況

ユニットバス内でも複数箇所にカビが確認されました。
湿気がこもりやすい水まわりは、発生源や再発の起点になりやすいため、周辺環境も含めた確認が重要です。
4-3. クロスの状況

クロス表面には変色が見られた一方で、クロス裏では目立った汚染が見受けられない箇所もありました。
このことから、見た目の印象だけで内部の汚染状況を判断するのは難しいことが分かります。
4-4. ベッドフレーム裏の状況

ベッドフレーム裏でもカビの付着が確認されました。
居室内では、壁面だけでなく家具まわりも汚染が広がりやすいため、周辺部材を含めた確認が必要です。
5. 含水率測定の結果|調査時点では表面は乾燥傾向

含水率測定では、建材の数値はおおむね0.5〜1.2%程度で、調査時点では表面に強い湿潤状態は見られませんでした。
一方で、付着菌検査ではボード裏で高い菌数が確認されており、常に濡れている状態というよりも、過去に一時的な湿気の滞留や結露が生じ、その影響が裏側に残っていた可能性が考えられます。
6. 調査結果から考えられる発生要因

今回の調査結果からは、カビの発生に複数の要因が重なっていた可能性が考えられます。
6-1. ボード裏など見えない部位での繁殖
表面よりもボード裏で高い菌数が出ていたことから、見えない内部側の環境がカビの増殖に適していた可能性があります。
このようなケースでは、表面だけを清掃しても原因部分が残るおそれがあります。
6-2. 一時的な結露や湿気滞留
調査時点では建材表面は乾燥傾向でしたが、裏側の汚染状況からは、過去に一時的な湿潤状態があったことがうかがえます。
空調の運転条件や温度差による結露が、発生要因の一つになった可能性があります。
6-3. ベッドや壁まわりへの胞子拡散
ベッド裏や壁面でも菌が確認されており、空間中に広がった胞子が家具や周辺部材に付着し、汚染が広がっていたと考えられます。
とくにペニシリウム属やアスペルギルス属は室内で広がりやすく、初期対応が不十分だと再発につながりやすくなります。
6-4. 低層階・換気条件の影響
建物全体としては、低層階ほど湿気の影響を受けやすく、換気や日照条件によってカビの発生しやすさに差が出ることがあります。
今回の事例でも、湿度・通気・温度差といった複数の条件が重なっていた可能性が考えられました。
7. 調査結果を踏まえた対応方針

調査結果を踏まえると、再発を防ぐためには見えている部分だけでなく、原因への対応まで含めて進めることが重要です。
7-1. 汚染状態を一度リセットする
すでに菌数が高い状態になっている場合、湿度管理だけでは十分な改善は見込みにくいと考えられます。
まずは除カビ・防カビ施工により、現在の汚染状態を一度リセットすることが重要です。
7-2. ボード裏・ベッド周辺を重点的に処置する
今回のように、裏側や見えにくい部位で高い菌数が出ている場合は、表面の拭き取りだけでは不十分です。
内部側を含めて重点的に処置することが、改善のポイントになります。
7-3. 湿度管理と換気の見直しを行う
湿度計による確認、除湿機の活用、空気の流れの改善などを行い、湿気が滞留しにくい環境を整えることが再発防止につながります。
とくに湿度が上がりやすい時期は、日常的に室内環境を確認することが大切です。
7-4. 結露対策と非使用時の運用を見直す
空調の設定や断熱条件を見直し、急激な温度差による結露を抑えることも重要です。
居室を使用していない期間は、除湿機や空気清浄機の活用なども検討するとよいでしょう。
8. まとめ|表面が乾いていても、裏側に原因が残っていることがある
今回の事例では、クロス裏は比較的低い数値だった一方で、ボード裏やベッド裏では高い菌数が確認されました。
このことから、カビの問題は表面の見た目だけでは判断しにくく、見えない部位を含めて調べることの重要性が分かります。
また、空気中のカビ、表面に付着した菌、建材の含水率をあわせて確認することで、汚染の広がり方や優先的に対応すべき箇所を整理しやすくなります。
人が長時間過ごす居室や施設では、早めに状況を把握し、原因に応じた対策を進めることが再発防止につながります。
カビでお困りの際は、ハーツリッチ株式会社(ハーツクリーン事業部)までご相談ください。
現地の状況確認から、原因調査、改善提案、再発防止まで一貫してご案内いたします。

